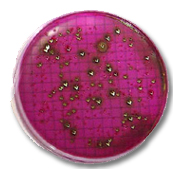
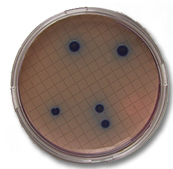

Protocole:
1. Au besoin, diluer l'échantillon et noter le facteur de dilution. Choisir une dilution permettant de donner entre 20 et 60 unités formant des colonies
(UFC) par 100 mL.
2. Prendre une boîte de Pétri de 47mm de diaètre contenant un papier absorbant. Au verso, identifier la date, vos initiales et toute autre information
pertinente.
3. Verser le contenu de l'ampoule de culture sur le papier absorbant.
- milieu m-Endo pour les coliformes totaux (rouge)
- milieu m-FC pour les coliformes fécaus ou thermotolérants (bleu)
4. Placer le support de la membrane filtrante sur un erlenmayer de filtration. Avec une pince stérile, déposer la membrane (0,45 um) sur le support
et fixer l'entonnoir.
7. Quand l'eau aura passé à travers la membrane, arrêter la pompe à vide, retirer la membrane et la déposer dans la boîte de Pétri.
8. Placer la boîte de Pétri dans l'incubateur approprié, en respectant les contraintes suivantes:
- coliformes totaux: les milieux m-Endo à 35°C pendant 24 heures.
- coliformes fécaux: les milieux m-FC à 44°C pendant 24 heures.
9. Après 24 heures, sortir la boîte de Pétri de l'incubateur et compter le nombre de colonies:
pour les coliformes totaux, les colonies sont de couleur:
- vert métallique, parfois avec une auréole rouge au centre
- vert mat très foncé
- rouge brun avec un léger reflet vert métallique
pour les coliformes fécaux, les colonies sont de couleur bleu pâle à bleu foncé
10.Calculer: UFC/100mL = nombre de colonies x 100 x facteur de dilution
Volume filtré (mL)
|















